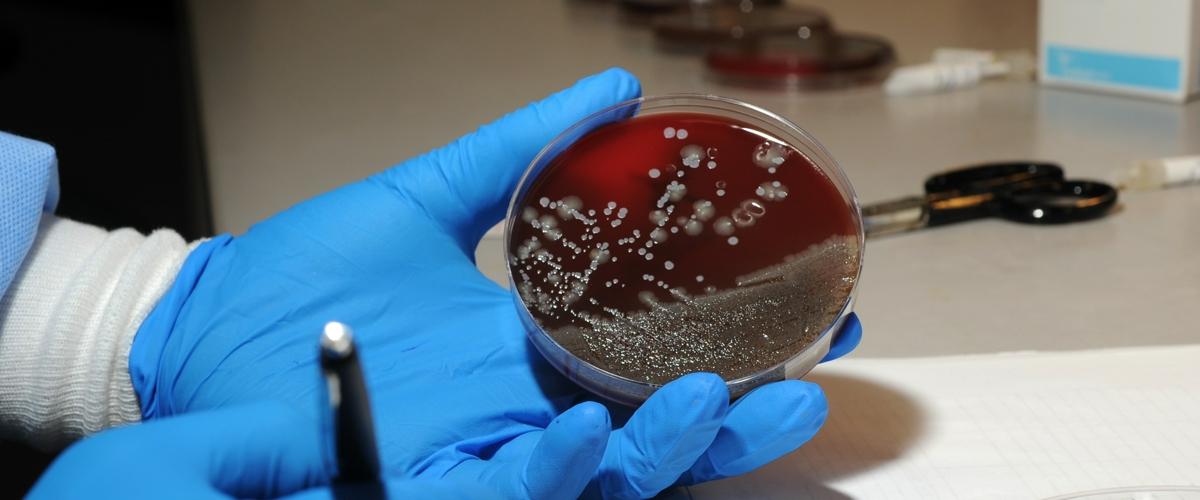
TODO:

Для постановки окончательного диагноза «рак поджелудочной железы» сегодня требуется биопсия — сложная инвазивная процедура, результаты которой полностью зависят от опыта врача. Выявить признаки рака на ранней стадии очень сложно, а вероятность пропустить болезнь даже на поздней стадии также всегда присутствует. Ученые из Австралии разработали анализ крови, который может упросить диагностику и повысить ее точность. Работа опубликована на Phys.org.
В основе теста лежит анализ внеклеточных везикул — крошечных пузырьков, которые выделяются клетками для коммуникации. Раковые клетки также умеют это делать. Используя высокоточный метод спектроскопии, разработанный учеными специально для этих целей, они идентифицировали три типа везикул, которые характерны для рака поджелудочной железы.
Технология оказалась настолько чувствительной, что ученым удалось обнаружить везикулы диаметром всего 113 нанометров. Это меньше 1% ширины волоса, уточнили авторы.
«Тест был очень точный для поздних стадий, а также для сложных случаев, где другие методы не могли обнаружить опухоль», — заявила соавтор исследования Юлин Ванг.
Сегодня определить рак даже на поздних стадиях бывает непросто. Именно из-за сложной диагностики рак поджелудочной железы считается одним из самых смертельных, а пятилетняя выживаемость составляет менее 10%.
Технология также эффективна для идентификации везикул, характерных для колоректального рака и опухоли мочевого пузыря, однако точность теста пока чуть ниже, по сравнению с диагностикой рака поджелудочной железы. Команда продолжит исследования для совершенствования метода.